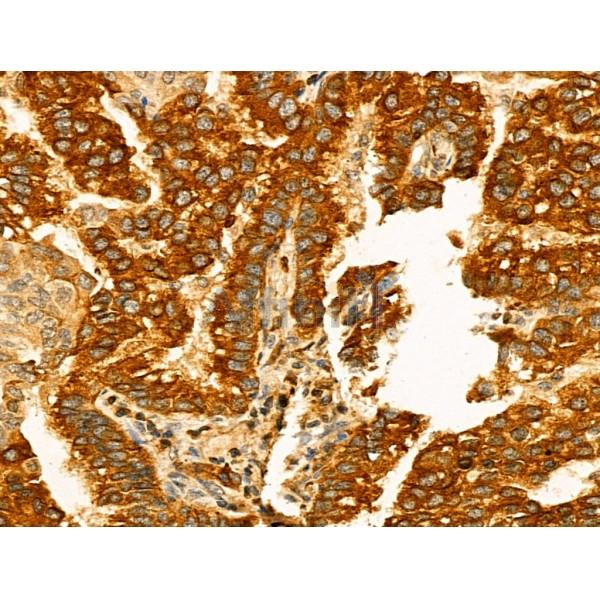
Kv1.4 Antibody - DF13119 at 1/100 staining Human lung cancer by IHC-P.

Kv1.4 Antibody - #DF13119
| Product: | Kv1.4 Antibody |
| Catalog: | DF13119 |
| Description: | Rabbit polyclonal antibody to Kv1.4 |
| Application: | WB IHC IF/ICC |
| Reactivity: | Human, Mouse, Rat |
| Prediction: | Pig, Bovine, Sheep |
| Mol.Wt.: | 73 kDa(Observed); 73kD(Calculated). |
| Uniprot: | P22459 |
| RRID: | AB_2846079 |
Related Downloads
Protocols
Product Info
*The optimal dilutions should be determined by the end user. For optimal experimental results, antibody reuse is not recommended.
*Tips:
WB: For western blot detection of denatured protein samples. IHC: For immunohistochemical detection of paraffin sections (IHC-p) or frozen sections (IHC-f) of tissue samples. IF/ICC: For immunofluorescence detection of cell samples. ELISA(peptide): For ELISA detection of antigenic peptide.
Cite Format: Affinity Biosciences Cat# DF13119, RRID:AB_2846079.
Fold/Unfold
;Voltage gated K+ channel HuKII; Fetal skeletal muscle potassium channel; HBK4; HK1; HPCN2; HUKII; Kcna4; KCNA4_HUMAN; KCNA4L; KCNA8; kv1.4; PCN2; Potassium channel 2; Potassium voltage gated channel shaker related subfamily member 4; Potassium voltage gated channel subfamily A member 4; Potassium voltage-gated channel subfamily A member 4; Rapidly inactivating potassium channel; Shaker related potassium channel Kv1.4; Type A potassium channel; Voltage gated potassium channel HBK4; Voltage gated potassium channel HK1; Voltage gated potassium channel subunit Kv1.4; Voltage-gated K(+) channel HuKII; Voltage-gated potassium channel HBK4; Voltage-gated potassium channel HK1; Voltage-gated potassium channel subunit Kv1.4;
Immunogens
A synthesized peptide derived from human Kv1.4, corresponding to a region within the internal amino acids.
Expressed in brain, and at lower levels in the testis, lung, kidney, colon and heart (PubMed:27582084). Detected in heart ventricle.
- P22459 KCNA4_HUMAN:
- Protein BLAST With
- NCBI/
- ExPASy/
- Uniprot
MEVAMVSAESSGCNSHMPYGYAAQARARERERLAHSRAAAAAAVAAATAAVEGSGGSGGGSHHHHQSRGACTSHDPQSSRGSRRRRRQRSEKKKAHYRQSSFPHCSDLMPSGSEEKILRELSEEEEDEEEEEEEEEEGRFYYSEDDHGDECSYTDLLPQDEGGGGYSSVRYSDCCERVVINVSGLRFETQMKTLAQFPETLLGDPEKRTQYFDPLRNEYFFDRNRPSFDAILYYYQSGGRLKRPVNVPFDIFTEEVKFYQLGEEALLKFREDEGFVREEEDRALPENEFKKQIWLLFEYPESSSPARGIAIVSVLVILISIVIFCLETLPEFRDDRDLVMALSAGGHGGLLNDTSAPHLENSGHTIFNDPFFIVETVCIVWFSFEFVVRCFACPSQALFFKNIMNIIDIVSILPYFITLGTDLAQQQGGGNGQQQQAMSFAILRIIRLVRVFRIFKLSRHSKGLQILGHTLRASMRELGLLIFFLFIGVILFSSAVYFAEADEPTTHFQSIPDAFWWAVVTMTTVGYGDMKPITVGGKIVGSLCAIAGVLTIALPVPVIVSNFNYFYHRETENEEQTQLTQNAVSCPYLPSNLLKKFRSSTSSSLGDKSEYLEMEEGVKESLCAKEEKCQGKGDDSETDKNNCSNAKAVETDV
Predictions
Score>80(red) has high confidence and is suggested to be used for WB detection. *The prediction model is mainly based on the alignment of immunogen sequences, the results are for reference only, not as the basis of quality assurance.
High(score>80) Medium(80>score>50) Low(score<50) No confidence
Research Backgrounds
Voltage-gated potassium channel that mediates transmembrane potassium transport in excitable membranes. Forms tetrameric potassium-selective channels through which potassium ions pass in accordance with their electrochemical gradient. The channel alternates between opened and closed conformations in response to the voltage difference across the membrane. Can form functional homotetrameric channels and heterotetrameric channels that contain variable proportions of KCNA1, KCNA2, KCNA4, KCNA5, and possibly other family members as well; channel properties depend on the type of alpha subunits that are part of the channel. Channel properties are modulated by cytoplasmic beta subunits that regulate the subcellular location of the alpha subunits and promote rapid inactivation. In vivo, membranes probably contain a mixture of heteromeric potassium channel complexes, making it difficult to assign currents observed in intact tissues to any particular potassium channel family member. Homotetrameric KCNA4 forms a potassium channel that opens in response to membrane depolarization, followed by rapid spontaneous channel closure. Likewise, a heterotetrameric channel formed by KCNA1 and KCNA4 shows rapid inactivation.
Cell membrane>Multi-pass membrane protein. Cell projection>Axon.
Expressed in brain, and at lower levels in the testis, lung, kidney, colon and heart. Detected in heart ventricle.
The N-terminus may be important in determining the rate of inactivation of the channel while the tail may play a role in modulation of channel activity and/or targeting of the channel to specific subcellular compartments.
The transmembrane segment S4 functions as voltage-sensor and is characterized by a series of positively charged amino acids at every third position. Channel opening and closing is effected by a conformation change that affects the position and orientation of the voltage-sensor paddle formed by S3 and S4 within the membrane. A transmembrane electric field that is positive inside would push the positively charged S4 segment outwards, thereby opening the pore, while a field that is negative inside would pull the S4 segment inwards and close the pore. Changes in the position and orientation of S4 are then transmitted to the activation gate formed by the inner helix bundle via the S4-S5 linker region.
Belongs to the potassium channel family. A (Shaker) (TC 1.A.1.2) subfamily. Kv1.4/KCNA4 sub-subfamily.
References
Restrictive clause
Affinity Biosciences tests all products strictly. Citations are provided as a resource for additional applications that have not been validated by Affinity Biosciences. Please choose the appropriate format for each application and consult Materials and Methods sections for additional details about the use of any product in these publications.
For Research Use Only.
Not for use in diagnostic or therapeutic procedures. Not for resale. Not for distribution without written consent. Affinity Biosciences will not be held responsible for patent infringement or other violations that may occur with the use of our products. Affinity Biosciences, Affinity Biosciences Logo and all other trademarks are the property of Affinity Biosciences LTD.